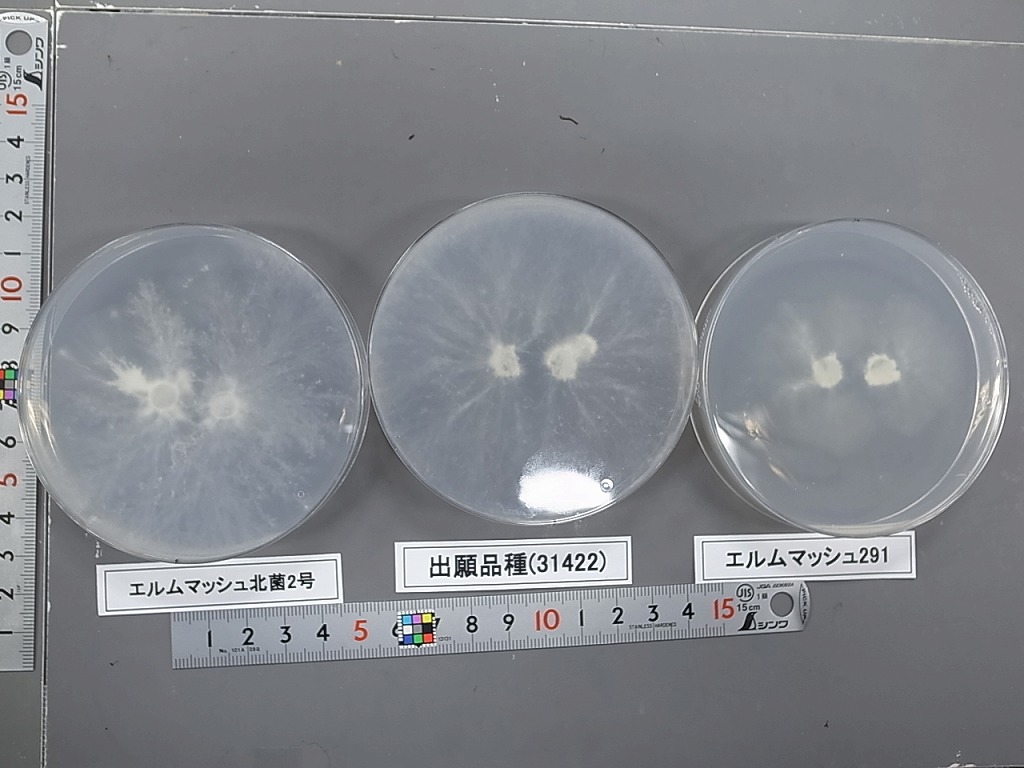

マイストア
変更
お店で受け取る
(送料無料)
配送する
納期目安:
2025.10.31 1:49頃のお届け予定です。
決済方法が、クレジット、代金引換の場合に限ります。その他の決済方法の場合はこちらをご確認ください。
※土・日・祝日の注文の場合や在庫状況によって、商品のお届けにお時間をいただく場合がございます。
つきのこ様への専用確認 プリーツマスク個包装 小さめ | マツキヨココカラオンラインストアの詳細情報
プリーツマスク個包装 小さめ | マツキヨココカラオンラインストア。品種登録迅速化総合電子化システム。品種登録迅速化総合電子化システム。品種登録迅速化総合電子化システム。商品の説明はありません
ベストセラーランキングです
近くの売り場の商品
カスタマーレビュー
オススメ度 4.5点
現在、3235件のレビューが投稿されています。

![[遊戯王] 月の女神エルザェム](https://static.mercdn.net/item/detail/orig/photos/m85689793541_1.jpg)









